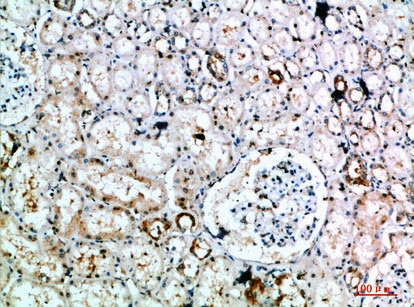
Immunohistochemical analysis of paraffin-embedded human-kidney, antibody was diluted at 1:200

Anti-DLEU7 antibody (51-100 aa) (STJ98807)
SPECIFICATIONS
ClonalityPolyclonal
HostRabbit
ConjugationUnconjugated
IsotypeIgG
ImmunogenThe antiserum was produced against synthesized peptide derived from the Internal region of human DLEU7 at the amino acid range 51-100
General Information
| Short Description | Rabbit polyclonal anti-Leukemia-associated protein 7 (51-100 aa) for use in IHC, IF and ELISA in Human, Rat and Mouse samples. Datasheet included with dilution recommendations, and related reagents. |
| Applications | IHC/IF/ELISA |
| Host | Rabbit |
| Reactivity | Human/Rat/Mouse |
| Note | STRICTLY FOR FURTHER SCIENTIFIC RESEARCH USE ONLY (RUO). MUST NOT TO BE USED IN DIAGNOSTIC OR THERAPEUTIC APPLICATIONS. |
Product Properties
| Clonality | Polyclonal |
| Isotype | IgG |
| Conjugation | Unconjugated |
| Concentration | 1 mg/mL |
| Purification | The antibody was affinity-purified from rabbit antiserum by affinity-chromatography using epitope-specific immunogen. |
| Dilution Range | IHC-P 1:50-200ELISA 1:10000-20000IF 1:50-200 |
| Formulation | Liquid in PBS containing 50% Glycerol, 0.5% BSA and 0.02% Sodium Azide. |
| Storage Instruction | Store at-20°C for up to 1 year from the date of receipt, and avoid repeat freeze-thaw cycles. |
Target Information
| Gene Symbol | DLEU7 |
| Gene ID | 220107 |
| Uniprot ID | LEU7_HUMAN |
| Immunogen | The antiserum was produced against synthesized peptide derived from the Internal region of human DLEU7 at the amino acid range 51-100 |
| Immunogen Region | 51-100 aa |
| Specificity | The antibody detects endogenous DLEU7 |
Additional Info
| Protein Name | Leukemia-Associated Protein 7Deleted In Lymphocytic Leukemia 7 |
| Database Links | |
| Cellular Localisation | |
| Alternative Antibody Names | Anti-Leukemia-Associated Protein 7 antibodyAnti-Deleted In Lymphocytic Leukemia 7 antibodyAnti-DLEU7 antibodyAnti-LEU7 antibody |
Information sourced from Uniprot.org